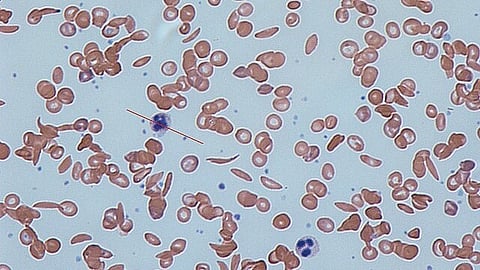
Novel Gene-editing therapy continues to show positive results in sickle cell disease patients (Representational image-Wikimedia Commons)

Researchers have presented the latest findings from a clinical trial aimed at discovering a cure for sickle cell disease, a painful genetic blood disorder with limited treatment options.
Conducted as part of the multicenter RUBY Trial, researchers shared data on the safety and effectiveness of renizgamglogene autogedtemcel (reni-cel, formerly known as EDIT-301), an experimental one-time gene editing cell therapy, among its 18 patients at the European Hematology Association 2024 Hybrid Congress (EHA) in Madrid, Spain.
This innovative treatment modifies a patient’s own blood-forming stem cells to correct the mutation responsible for sickle cell disease.
The 18 patients – two of whom were treated at Cleveland Clinic Children’s – underwent a procedure where their stem cells were first collected for gene editing. They then received chemotherapy to clear remaining bone marrow, making room for the repaired cells which were later infused back into their body.
The treatment was well-tolerated with no serious side effects reported. Following treatment, all patients successfully regained their white blood cells and platelets. Importantly, all patients have remained free of painful events since treatment, and those followed for five months or greater have seen their anemia resolve.
A significant milestone of the trial is the first use of CRISPR/Cas12a gene-editing technology in a human study to alter the defective gene responsible for sickle cell disease. This precision tool is used to modify blood stem cell genomes to enable robust and healthy blood cell production.
In the United States, between 1 million to 3 million people carry the sickle cell trait, while approximately 100,000 individuals have sickle cell disease. This trait and disease are more common among certain ethnic groups, including African Americans, where approximately 1 in every 365 babies are born with sickle cell disease.
Sickle cell disease is a genetic blood disorder that causes red blood cells to be misshapen like a sickle. Normal red blood cells are round and carry oxygen smoothly through blood vessels. In sickle cell disease, the abnormal cells block blood flow and break apart easily, leading to problems like severe pain, liver and heart issues, and a shorter life span, typically in the mid-40s. Medications can help manage the disease, but a cure is possible only through a blood or marrow transplant, which has risks and often requires a sibling donor.
(Newswise/MJ)